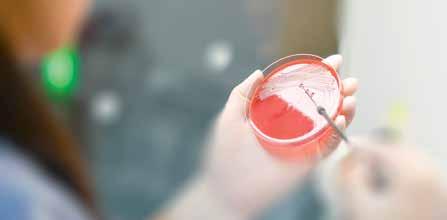

#EstamosATiempo: De diversificar los traslados entre Querétaro y CDMX


#EstamosATiempo: De diversificar los traslados entre Querétaro y CDMX

#SúperDeportivo Tigres ya está en la final

PÁG.
#ElObservador $10.00 Editado por la empresa FOTO: CUARTOSCURO DOMINGO 21 de mayo de 2023 Año 20 No. 7100 #LoMejor PÁG. 03 aldialogo.mx

Para esta semana y durante el resto de mayo, se desarrollará una serie de espectáculos y talleres en la ciudad como en el interior del estado PÁG. 04
Víctor Pérez, presidente de la Comisión de Comunicaciones y Transportes de la Cámara de Diputados, señaló que analizan la estructura existente para el proyecto. /Redacción PÁG. 03
#Fotorreportaje El volcán más vigilado

EN EL
de Cristo. PÁG. 12
EDITORA: GINA FERNÁNDEZ
Redacción
El municipio de Querétaro, a través de la Secretaría de Servicios Públicos municipales, se unió a la megajornada de limpieza en la zona de Hércules de la delegación Villa Cayetano Rubio, en la que se contó con la participación de voluntarios de la sociedad civil y una cuadrilla de 33 personas pertenecientes a la secretaría.
La capital queretana contribuyó activamente a esta
ORGULLOSAMENTE PRIMER MEDIO DE COMUNICACIÓN CERTIFICADO EN QUERÉTARO Y BAJÍO
Se reiteró el compromiso por tener una ciudad limpia
megajornada con el despliegue de equipos y maquinaria especializada, entre los que se encontraban una retroexcavadora, una camioneta de rodillas y dos volteos, los cuales permitieron llevar a cabo diversas tareas de limpieza de manera eficiente.
Además, durante la jornada se realizaron labores de desmalezado, recolección de tiliches, escombro y llantas, donde se logró recolectar un total de cuatro toneladas de residuos.
Directorio
El presidente municipal de El Marqués, Enrique Vega, acompañado del secretario de Desarrollo Social, Agustín Dorantes, y la secretaria del Trabajo estatal, Liliana San Martín, encabezó la reinauguración del edificio del Sindicato de Trabajadores al Servicio del municipio de El Marqués, ‘Lic. Ramiro Ramírez

Editado por la empresa AD Comunicaciones S de RL de CV
CONSEJO EDITORIAL
Hans Alfonso Frei Nieto, José de la Garza Pedraza, Juan Germán Torres Landa García, Verónica Valverde, Alejandra Vega Reyes, Luis Miguel Rubín Colea, María Genoveva Anaya Saavedra, Mariana Vidales Guerrero, Óscar Peralta Casares, Pedro Ruiz Velasco, Mauricio Sánchez Botello
DIRECTOR GENERAL EDITORIAL
Miguel Ángel Flores García mflores@adcomunicaciones.mx
JEFATURA DE INFORMACIÓN
Marittza Navarro
CONTENIDOS editores@amqueretaro.com
Miguel Tierrafría
Magdiel Torres
Georgina Fernández
Juan Carlos Machorro
Mauricio del Ángel
Berenice Rodríguez
JEFATURA DE REPORTEROS Salvador Castillo
EDITORA GENERAL VSD! Y WEEKEND Arcelia Guadarrama
ARTE E IMAGEN
Marco A. Rodríguez
Juan Palma
Daniela Ramírez Diseño Editorial
AMQUERETARO.COM internet@amqueretaro.com
Lorena Rudo Editora Web
Estefany González Community Manager
DIRECTOR COMERCIAL Antonio Collado Prieto acollado@adcomunicaciones.mx
SUSCRIPCIONES Andrea Jiménez suscripciones@adcomunicaciones.mx
CIRCULACIÓN Emmanuel Hernández pagos@adcomunicaciones.mx
ADMINISTRACIÓN
Mariana Picazo administracion@adcomunicaciones.mx
ALIANZAS DE COLABORACIÓN
publicidad@adcomunicaciones.mx
Móvil: (442) 479 14 89
de Licitud de Título y Contenido número 17050, de los cuales EDITORIAL MARTINICA, S.A. de C.V. es titular y autoriza su uso a AD COMUNICACIONES, S. DE R.L. DE C.V. quien tiene su domicilio en Avenida
Constituyentes Nº109, Interior 11, Colonia Carretas. C.P. 76050, Santiago de Querétaro, Querétaro. Domicilio de la Publicación: Calzada de los Héroes Número 708 Colonia La Martinica C.P. 37500 León, Guanajuato.
Imprenta: El Universal Compañía Periodística Nacional, S.A. de C.V. Bucareli Número 8, Colonia Centro, Alcaldía Cuauhtémoc, Ciudad de México C.P. 06040. Distribuidor: AD COMUNICACIONES, S. DE R.L. DE C.V. Avenida Constituyentes Nº 109, Interior 11, Colonia Carretas. C.P. 76050, Santiago de Querétaro, Querétaro. Servicios informativos: Cuartoscuro, AP, Mexsport, Istockphoto. Prohibida la reproducción total o parcial del contenido de esta edición.
Oficina: (442) 291 99 00
Certificado de Circulación, Cobertura y Perfil del Lector folio 01058-RHY emitido por
Ramírez’. REDACCIÓN

El secretario de movilidad en el municipio de Querétaro, Rodrigo Vega, informó que se sigue evaluando el censo de bicicletas en la capital en conjunto con organizaciones de ciclistas y expertos en el tema. Lo anterior luego de recordar que quedó descartado el tema del reemplacamiento de las mismas, pero reiteró que se busca contar con un padrón del número de bicicletas en la ciudad mediante algún distintivo como un código QR.


LAS

Se requiere de un nuevo trazo y derechos de vía, convocando a licitaciones nacionales e internacionales
Quadratín Querétaro
Para revivir el proyecto del tren entre Ciudad de México (CDMX) y Querétaro es posible usar las vías existentes con trenes de velocidad promedio entre 80 y 100 kilómetros por hora, algo cercano a los vagones de alta velocidad, comentó Víctor Pérez Díaz, presidente de la Comisión de Comunicaciones y Transportes de la Cámara de Diputados.
“Aprovechando la infraestructura y derecho de vía de la concesionaria CPKC, que ya anticipó su colaboración, se puede usar esa infraestructura ya instalada para que el proyecto avance rápido y tengamos, en el corto plazo, ese servicio de pasajeros que es urgente ante la sobresaturación de la carretera y que puede ser una ruta alterna”, explicó.
El legislador destacó que este proyecto se incluyó en el paquete de infraestructura para 2021 con una inversión de más de 51 mil
Realizarán concesiones de derechos de vía. ESPECIAL



SE PRETENDE QUE SEA UN SISTEMA MÁS ORGANIZADO PARA DETONAR LA INVERSIÓN EN EL SECTOR Y, ASÍ, IMPULSAR LA MODERNIZACIÓN
millones de pesos, pero no se concretó a pesar de que beneficiaría a 25 millones de mexicanos de la zona centro del país.
En septiembre, se presentará una iniciativa de reforma a la Ley Reglamentaria del Servicio Ferroviario parafortalecer la regulación.
#LoMejorDeAlDiálogo
Te presentamos los mejores comentarios de la semana en las ediciones de Al Diálogo.

“¡Ja, ja!
¿Saben lo que eso implica?
¿No debería decir que ‘son molestados’?
¿Qué porcentaje es acosador?”.
“Desgraciadamente esto se debe a que la mayoría de los docentes no están capacitados para llevar este tema o cómo manejarlo, muy cierto, la principal educación en valores y respeto viene desde casa, pero la responsabilidad, una vez ingresando a las instalaciones de una institución, la responsabilidad, quieran o no, es de los maestros, desgraciadamente también Usebeq, respecto a este tema tan importante, no ha hecho nada, han pasado tantos casos aquí en Querétaro respecto al ‘bullying’ y las autoridades correspondientes no hacen nada, a Usebeq, solo le preocupa el prestigio de su escuela".
“Desafortunadamente muchas personas no saben lo que implica retirar dinero de la Afore y se hace fácil retirar cuando hay desempleo sin pensar que después deben de trabajar más para recuperar lo que les prestaron”.

“Excelente información, realmente pocos podemos contar con un seguro de vida por los costos y la cultura de no prevenir”.

14 CRUZADA CENTRAL POR EL TEATRO
● 21 de mayo
● 13:00 horas
● Del misterio del pizarrón
● Atabal Creación Artística AC
● Querétaro
● Cuota: 100 pesos
● Compra anticipada: 80 pesos
● Para toda la familia
● Antigua estación del ferrocarril
14 CRUZADA
CENTRAL POR EL TEATRO
● 21 de mayo
● 20:00 horas
● Río Ánimas
● Cafuné Teatro
● Querétaro
● Cuota: 100 pesos
● Compra anticipada: 80 pesos
● Adolescentes y adultos
● Foro escénico del Museo de la Ciudad PROYECCIÓN Y CHARLA DE CORTOMETRAJES DE ANIMACIÓN DE CINE KIXTA

● Presentados por su director Sebastián Jaiovi
● Dirigido a niñas y niños de 6 a 12 años
● Viernes 25 de mayo
● 16:00 horas
● En las instalaciones del Museo de la Ciudad de Querétaro
NOCHE DE TERTULIA
● Todos los jueves
● 20:00 horas
● Entrada gratuita
● Museo Anbanica de Historia
CLÍNICA DE CIANOTIPIA
● Sábado 3 de junio
● De 9:00 a 11:00 horas
● Jóvenes de 18 a 29 años
● Cupo limitado
● Centro Queretano de la
Querétaro
DOMINGO 21 DE MAYO DE 2023
Redacción
Para esta semana y durante el resto de mayo, se desarrollarán una serie de espectáculos y talleres en la ciudad como en el interior del estado. Esta oferta cultural es variada, pues hay eventos para toda la familia, así como para públicos específicos.
Uno de los eventos que se realizará próximamente será la ‘Clínica de Cianotipia’. Esta clínica se enfocará en un acercamiento educativo para los asistentes de manera que tengan una introducción general a esta técnica inventada en el siglo XIX y que pervive en la actualidad.
Las fechas para este evento son los sábados 20 de mayo y 3 de junio en un horario de 9:00 a 11:00 horas y está dirigido para un público joven de entre 18 a 29 años en el Centro Queretano de la Imagen, ubicado en la calle Juárez Sur #66 en el Centro Histórico.
les trabajan de la mano de diseñadores de moda para visibilizar los textiles tradicionales del estado de Querétaro.

La pasarela se llevará a cabo en el Centro de las Artes de Querétaro, ubicado en la calle Arteaga, número 89, colonia Centro, a las 19:00 horas el próximo miércoles 24 de mayo. Este evento es con causa y lo recaudado se destinará a la compra
de materiales para los artesanos queretanos. Los precios van desde 600 hasta dos mil pesos. Mayores informes en: (442) 2519850 Ext. 1035 También habrá puestas en escena con el festival 14 Cruzada Central por el Teatro con piezas como ‘Del misterio del pizarrón’ y ‘Río Ánimas’ que se realizarán el 21 de mayo a las 13:00 y 20:00 horas, respectivamente.
Otra de las actividades que llaman la atención es la pasarela textil artesanal-contemporánea ‘Nthoki ‘yē, ma mengu’ (Hecho a mano, mi familia, en lengua Hñäñho). Este es un evento donde artesanos loca - Durante esta
DIAGNÓSTICO INTEGRAL A SECULT
La secretaria de Cultura del estado, Marcela Herbert, reiteró su disposición al diálogo y los acuerdos al recibir de la comunidad artística y cultural queretana un diagnóstico con acciones afirmativas para abordar la problemática que enfrenta ese gremio.
Imagen
● Juárez Sur #66, Centro Histórico, Casa de los Leones
EXPERIMENTA LA HISTORIA SENSITIVA
● 18 de mayo
● 17:45 horas
● Centro de las Artes de Querétaro
● Arteaga 89, Centro Histórico
TALLER INTENSIVO GESTIÓN Y PRODUCCIÓN
PARA LAS ARTES
ESCÉNICAS
● A cargo de Miriam
Balderas Mendonza
● Del 22 al 25 de mayo
● De 13:00 a 18:00 horas
● Salón de usos múltiples
● Centro de las Artes de Querétaro
PASARELA TEXTIL ARTESANALCONTEMPORÁNEA
‘NTHOKI ‘YĒ, MA
MENGU’ (HECHO A MANO, MI FAMILIA)
● Segunda edición
● 24 de mayo.
● 19:00 horas
● Cuota sugerida:
● zona naranja: 600 pesos
● zona verde: 800 pesos
● zona amarilla: 1,000 pesos
● zona rosa: 1,500 pesos
● zona azul: 2,000 pesos
● Centro de las Artes de Querétaro, Arteaga 89, Centro.
● Mayores informes en: (442) 2519850 Ext. 1035
LUNES DE CRONISTAS
● Relatos de Querétaro y su patrimonio cultural
● David Felipe Gutiérrez Ugalde, historiador
● ‘Un oasis en el semidesierto queretano: la hacienda Ajuchitlán el Grande durante el Porfiriato’
● 22 de mayo
● 16:00 horas
La cartelera cultural tendrá una variada presencia de grupos artísticos que ofrecen espectáculos para todas las edades y de diversas disciplinas artísticas en la ciudad y en el estadosemana se llevarán a cabo diversos talleres. ESPECIAL
● Centro de las Artes de Querétaro
CUÉNTAME UN DRAMA
● La ópera irreverente
● Compañía de ópera Sing
Von Seele
● 26 de mayo
● 20:00 horas
● Centro de las Artes de Querétaro
KAWAII-RITA
● Contemporización de la ópera ‘Rita’
● De Galeano Donizetti
● Compañía de ópera Sing
Von Seele
● 20 de mayo
● 19:00 horas
● Centro de las Artes de Querétaro
TALLER
INTRODUCCIÓN
AL GRABADO:
LINOGRABADO Y XILOGRABADO
● Grupo matutino: Alix Yolitzin
● Grupo vespertino: Mari
Mariel
● Del 29 de mayo al 17 de julio (8 clases)
● Grupo matutino: martes de 11:00 a 14:00 horas
● Grupo vespertino: martes de 16:00 a 19:00 horas
● Taller de grabado ‘Los caminantes’
● Centro de las Artes de Querétaro
TALLER PINTURA CONTEMPORÁNEA
PARA JÓVENES Y ADULTOS
● A cargo de Karla González
● Del 2 al 30 de junio
● Todos los viernes de 15:00 a 18:00 horas
● Centro de las Artes de Querétaro
FESTIVAL MÚSICA
RAÍZ MÉXICO
● Región centro
● Rockeando el folclor

● Convertario ‘Fusión acústica-eléctrica de guitarras
Fue en 2010 cuando Pixies, la legendaria banda de rock alternativo, ofreció su primer ‘show’ en la Ciudad de México, la agrupación regresó para vivir un reencuentro lleno de emoción, nostalgia y mucho rock ante tres mil de sus fanáticos.



Autor: Oliver Pötzsch
Editorial: Planeta
Sinopsis: Viena, 1894. En un sarcófago del Museo de Historia de la ciudad aparece, momificado, el cuerpo del profesor Alfons Strössner, uno de los mayores egiptólogos del mundo. Leopold von Harzfeldt será el encargado de la investigación y, pronto descubrirá que, de los cuatro miembros de su última expedición a la Tierra Negra, tres han fallecido en extrañas circunstancias.
Autora: Alaitz Leceaga
Editorial: Planeta
Sinopsis: Mina Índigo es la médium más solicitada de Barcelona. En su palacete del céntrico pasaje de Permanyer, organiza sesiones espiritistas para ricas damas de la alta sociedad, pero, en realidad, es una experta investigadora que usa sus contactos para obtener información comprometedora de sus clientes.
Autoras: Marie Benedict y Victoria Christopher Murray

Editorial: Planeta
Sinopsis: Gracias a su pasión por los libros, Belle da Costa Green se ha vuelto, con tan solo veinte años, la bibliotecaria más joven de la universidad de Princeton. Sin embargo, un golpe de suerte mayor está por impulsar su carrera: el famoso millonario J. P. Morgan la quiere para encargarle una colección de manuscritos, libros y obras de arte.

El escritor británico Martin Amis falleció a los 73 años de edad en su residencia en Lake Worth en Florida, Estados Unidos.
La cantante Lupita D’Alessio se presentó con un gran éxito y lleno total en el Auditorio Josefa Ortiz de Domínguez, donde deleitó a sus fanáticos con su inconfundible entrega e interpretación.
La ‘leona dormida’ anunció su gira de despedida, ‘Gracias’, misma que incluye un recorrido musical por sus grandes éxitos así como los más importantes escenarios, por lo que Querétaro no podía faltar.
La velada comenzó con la presentación de Ernesto D’Alessio, su invitado especial, quien interpretó temas que hicieron famosa a su mamá, como ‘Tiempo de rosas’.
Fue cuando apareció, en el escenario, Lupita D’Alessio para interpretar, a lado de su hijo, éxitos como ‘Ni guerra, ni paz’.
Para finalizar, la intérprete hizo gala de su voz y su histrionismo cantando ‘Mudanzas’ y ‘Mentiras’ y, así, se despidió de su público.
“Estoy feliz de llenar este lugar. Me voy feliz de Querétaro. Gracias, hasta siempre”, mencionó.
La cantante se entregó a su público.
HAY 25 MILLONES DE HABITANTES VIVIENDO A SUS PIES


Texto: AP
Fotos: Cuartoscuro/AP
Cada vez que la cumbre del Popocatépetl lanza fuego o bocanadas de ceniza más fuertes que las normales, como ocurrió esta semana, lo hace bajo la atenta mirada de una docena de científicos. Nada pasa desapercibido porque millones de personas, e incluso el trafico aéreo, pueden verse afectados si entra en erupción: 11 pueblos cerraron, esta semana, sus escuelas debido a la ceniza en el aire, que se acumulaba también en calles y automóviles.



Desde hace casi 25 años, la
Desde hace casi 25 años, la ‘montaña que humea’, como lo llamaban los pueblos prehispánicos, es el volcán más vigilado de México
‘montaña que humea’, como lo llamaban los pueblos prehispánicos, es el volcán más vigilado de México: siete cámaras –una de ellas térmica–, 12 sismógrafos, seis estaciones para medir deformaciones en sus laderas, dos sensores infrasónicos y siete estaciones meteorológicas envían datos las 24 horas, 365 días al año, a un centro de control situado a 80 kilómetros en el sur de la Ciudad de México.

OBTUVIERON TRES PRESEAS
Excélsior
El día para México en la Copa del Mundo de Tiro con Arco terminó con representación azteca en cada uno de los niveles del podio, donde, en la rama femenil se consiguió el oro tras vencer a Corea del Sur, la plata en la Varonil al caer frente a Países Bajos y, en una emocionante definición de muerte súbita, Andrea Becerra y Miguel Becerra obtuvieron el bronce ante Italia.
Andrea Becerra, Dafne Quintero y Ana Hernández pusieron el nombre de México en lo más alto de la Copa del Mundo de Tiro con Arco, celebrada en Shanghái, China, tras vencer a Corea del Sur con un marcador de 230 a 226; “vamos por más primeros lugares”, afirmó Quintero tras el oro obtenido.

Pese a que, durante la transmisión y en redes sociales, se especulara de la “facilidad” para subir a lo más alto del podio, Andrea Becerra dio el justo valor al mérito de las asiáticas y resaltó las cualidades de las arqueras mexicanas.
“Creo que no fue fácil, Corea es un equipo increíble y sabíamos que teníamos que tirar bien para poderles ganar”, afirmó.
Por su parte, México sumó una
Destacaron las cualidades de las arqueras. ESPECIAL
segunda medalla en la rama varonil, donde Juan del Río, Miguel Becerra y Sebastián García se llevaron la plata al caer ante Países Bajos.
Durante el primer set, los arqueros de ambas naciones tiraron para un total de 58 puntos, mientras que, en el segundo, fueron las flechas europeas quienes tuvieron una mayor certeza y aventajaron a los aztecas por tres. A pesar de que, en el último episodio, México se acercó, el resultado favoreció a los neerlandeses, quienes subieron a lo más alto del podio tras el 172-174 final.
Andrea Becerra y Miguel Becerra representaron a México en la prueba de equipo mixto del arco compuesto, donde llegaron a la contienda por la presea de Bronce ante Italia, representado por Elisa Roner y Elia Fregnan.
El país contó con representación en la rama femenil, varonil y mixta

Con gol de Sebastián Córdova, Tigres eliminó a Monterrey, superlíder del Clausura 2023, y jugarán una nueva final. Los universitarios aprovecharon un centro al área y, con un cabezazo de Córdoba, aseguraban su paso a la final de la fiesta del futbol mexicano. Monterrey fue hacia el frente a buscar el gol del empate y su pase a la final, pero los felinos cerraron bien los espacios. REDACCIÓN
AP
Holger Rune dio seguimiento a su más reciente victoria ante Novak Djokovic con otra impresionante actuación al dar la vuelta para vencer por parciales de 6-7 (2), 6-4 y 6-2 a Casper Ruud para alcanzar la final del Abierto de Italia.
Será la tercera final en arcilla para Rune, después de que el danés de 20 años ganó el título en Munich y perdió ante Andrey Rublev por el título en el Masters de Monte Carlo.

“Juega sin miedo, toma la bola rápido, lo cual es impresionante en arcilla”, recono-
ció Ruud. “No es normal hacerlo muy bien en arcilla por tienes malos botes”, agregó.
En la final, Rune enfrentará al ganador del duelo entre Stefanos Tsitsipas y Daniil Medvedev, que fue suspendido cuando estaban empatados 4-4 en el primer set debido a la lluvia.
Más tarde, la campeona de Wimbledon Elena Rybakina se verá ante la ucraniana Anhelina Kalinina en la final femenina.
Rune, séptimo de la clasificación, venía de vencer al seis veces campeón de Roma, Novak Djokovic, su segunda victoria ante el serbio en menos de seis meses.
Ruud alcanzó la final de Roland Garros el año pasado y que perdió ante Rafael Nadal, quien anunció que no competirá en París debido a un problema en la cadera que lo ha tenido fuera desde enero.
Rune mejoró a una marca de 7-1 ante rivales que se encuentran entre los cinco mejores del mundo.
“Juego mi mejor tenis cuando enfrentó a los mejores tenistas del mundo”, admitió.
Andrea Becerra,
y Ana Hernández pusieron el nombre de México en lo más alto

MÓDULO DE ALUNIZAJE
La compañía de cohetes de Jeff Bezos obtuvo un contrato de la agencia espacial NASA para llevar astronautas a la Luna dos años después de perder ante SpaceX. Blue Origin recibió un contrato de tres mil 400 millones de dólares para liderar un equipo que desarrolle un módulo de alunizaje llamado Blue Moon. Se usará para transportar astronautas a la superficie lunar a partir de 2029 luego de un par de misiones con la tripulación de SpaceX de Elon Musk. La NASA llevará a los astronautas a la órbita lunar utilizando sus propios cohetes y cápsulas, pero desea que las empresas privadas se hagan cargo a partir de ahí.

Redacción
La Secretaría de Agricultura y Desarrollo Rural federal puso en marcha lineamientos e instrumentos para la conservación y uso sustentable de los polinizadores como las abejas, que contribuyen con el 10 por cierto de la riqueza genética, biodiversidad y ecosistemas del país, resaltó el titular de la dependencia, Víctor Villalobos Arámbula.
El país es el quinto exportador global de miel de abeja
México cuenta con la iniciativa de política pública denominada Estrategia Nacional para la Conservación y Uso Sustentable de los Polinizadores (ENCUSP) y se da a la tarea de resaltar el papel relevante de las abejas como polinizadores y su preservación a favor de la agricultura, la seguridad alimentaria y la biodiversidad.

La federación trabaja en un esquema que permita hacer una adecuada coordinación entre las actividades y prácticas agrícolas, particularmente lo que tiene que ver con el uso de agroquímicos, la producción de miel y el papel de los polinizadores.
La dependencia se ocupa del manejo adecuado de los polinizadores con el cambio a prácticas agrícolas sustentables en frutales y hortalizas para evitar poner en riesgo la polinización y abonar a la alimentación de la población.
PROHÍBEN TIKTOK EN MONTANA, EUA

El gobierno estatal firmó una ley que prohíbe el uso de la red social, es el primer estado en restringir la plataforma.
De acuerdo con un estudio publicado en The Lancet en 2019 la carga mundial asociada con las infecciones resistentes a los medicamentos se estimó en 4.95 millones de muertes, de las cuales, la resistencia antimicrobiana (Ram) fue la causa directa de, al menos, 1.27 millones. Este número aumentará a menos que se tomen medidas para frenarla.
La infección por la COVID-19 ha alimentado aún más este problema y, de seguir esa tendencia, la mortalidad puede incrementarse a 10 millones por año para 2050.
La llamada era moderna de los antibióticos comenzó en 1910 con el primer uso clínico de un antimicrobiano sintético, el medicamento salvadoreño a base de arsénico fabricado por Paul Ehrlich, para tratar la sífilis. Desde
entonces, los antimicrobianos, incluidos los antibióticos, han salvado innumerables vidas y han contribuido significativamente al control de enfermedades infecciosas que, alguna vez, dominaron la morbilidad y la mortalidad humanas.
Ahora, el aumento global de los microorganismos resistentes a los antibióticos es una de las amenazas para la salud.
SE DEBEN DEFINIR LOS ASPECTOS FUNCIONALES DE LA MICROBIOTA Y DE PROTECCIÓN
El llamado a la acción contra la amenaza de la resistencia a los antibióticos inspiró la creación del Consejo Asesor Presidencial para Combatir las Bacterias Resistentes a los Antibióticos de Estados Unidos, así como una iniciativa de las Naciones Unidas.
Existe un programa contra patógenos resistentes a múltiples fármacos

Evangelio
DEL SANTO EVANGELIO SEGÚN SAN MATEO: 28, 16-20
En aquel tiempo, los once discípulos se fueron a Galilea y subieron al monte en el que Jesús los había citado. Al ver a Jesús, se postraron aunque algunos titubeaban. Entonces, Jesús se acercó a ellos y les dijo: “Me ha sido dado todo poder en el cielo y en la tierra. Vayan, pues, y hagan discípulos a todos los pueblos, bautizándolos en el nombre del Padre y del Hijo y del Espíritu Santo y enseñándoles a cumplir todo cuanto yo les he mandado y sepan que yo estaré con ustedes todos los días hasta el fin del mundo”.

Reflexión
PADRE NICOLÁS SCHWIZER INSTITUTO DE LOS PADRES DE SCHOENSTATT
El Evangelio de hoy nos señala: “Sabed que estoy con vosotros todos los días hasta el fin del mundo” (Mt 28,20). El Señor está con nosotros yya no nos abandonará jamas. Pero, ¿cómo está Cristo con nosotros, en nuestra tierra?
Cristo está presente.
Cristo está aquí, en la tierra, con nosotros y ya no nos abandonará jamás. Está presente en los sacramentos, sobre todo en la Eucaristía. Está presente en la comunidad cristiana. Está presente en nuestro corazón que es un templo de Cristo y del Dios Trino.
La Ascensión del Señor, que celebramos hoy, nos quiere revelar algo más que su presencia invisible
en medio de nosotros. Nos revela cómo se va a acabar nuestro destino, nuestra vida terrenal. Creo que esta es una pregunta que nos inquieta a todos y la fiesta de hoy nos da la respuesta: nuestro final será una ascensión.
Algún día, nos encontraremos en el cielo, lo mismo que ahora estamos reunidos aquí. Nuestra presencia aquí, en esta misa dominical, no hace más que prefigurar, anunciar y preparar esa gran asamblea final en torno al Señor. Dentro de unos momentos, la vida nos dispersará, pero será solo algo transitorio, hasta que llegue la hora de nuestra ascensión final. Todo es transitorio: alegrías, tristezas, bienes…
Porque todo lo que pasa aquí abajo en esta tierra es transitorio. Cuántas veces nos desanimamos por cualquier contrariedad, cualquier sufrimiento y cruz, diciendo: “no es posible que Dios exista y permita estas cosas, no es posible que Dios dirija nuestra vida y que la transforme de esta manera”. Sí, es verdad que las cosas no nos resultan siempre fáciles. Pero esperemos, tengamos paciencia, no juzguemos hasta haber visto el final porque
sabemos, ya por experiencia, que, después de la Pasión y del Calvario, viene siempre la Resurrección y la Ascensión.
Por eso, toda tristeza es transitoria. Somos desgraciados, pero solamente por un tiempo breve.
¿Por qué recé y no me escuchó Dios? Porque Dios se reserva el derecho de darme muchas cosas y mucho mejores que las que yo me atreví a pedirle.
¿Por qué sigo enfermo, sin fuerzas? Porque pronto quedaré curado para siempre.
¿Por qué tengo que lamentar la muerte de una persona querida? o ¿por qué la vida me separa de lo únicos con quienes me gusta vivir? Porque pronto me encontraré reunido para siempre.
Queridos hermanos, en esta Eucaristía de la Ascensión, muchos de nosotros vamos a comulgar dentro de un rato. Así, vamos a prefigurar aquel día feliz en que todos nosotros nos reuniremos definitivamente en torno al Señor.
Vamos a anticipar el encuentro final en la Casa del Padre, con la Virgen María y con todos los hermanos en la Alianza de Amor y sin tener que separarnos ya nunca más.
Hacia nuestra propia ascensión
CRISTO REY
Madero 297 Pte., Niños Héroes
7:00, 8:00, 10:30, 12:00, 17:00 y 18:30 hrs.
DIVINA PASTORA
21 de Marzo 134-B
8:00, 9:00, 10:00, 12:00, 18:00, 19:00 y 20:00 hrs.
LA PURÍSIMA
CONCEPCIÓN
Av. del Río 1, Hércules
7:00, 9:00, 12:00, 17:00, 18:00 y 20:00 hrs.
MINISTERIO DE PENTECOSTÉS
Av. Ingenieros esq. Cimatario, El Marqués
8:00, 10:00, 12:00, 13:30, 17:00, 18:30, 20:00 y 21:00 hrs.
NUESTRA SEÑORA DE GUADALUPE
Blvr. de las Américas 111, Reforma Agraria
7:00, 8:30, 10:00, 12:00, 18:00 y 19:30 hrs.
NUESTRA SEÑORA DE LA PAZ
Calle Agua 259, Satélite
8:00, 11:00 17:00, 18:30 y 20:00 hrs.
NUESTRA SEÑORA DEL ROSARIO DEL RAYO
Luis M. Vega 57, Cimatario
8:00, 9:00, 11:00, 12:00, 13:00,
18:00, 19:00 y 20 hrs.
NUESTRA SEÑORA DE SAN JUAN DE LOS LAGOS
Calle 25 y 8, 405, Lomas de Casa Blanca
7:00, 10:00, 12:00, 17:00, 18:00 y 19:00 hrs.
SAGRADA FAMILIA
Blvr. Jardines de la Hacienda 710
8:00, 10:00, 13:00, 18:00 y 20:00 hrs.
SAN AGUSTÍN DEL RETABLO
Calz. del Retablo y Jericó
8:00, 12:00 y 18:00 hrs.
SAN FRANCISCO GALILEO
Madero 13, El Pueblito, Villa Corregidora
6:00, 10:00, 12:00, 13:15, 19:00 y 20:00 hrs.
SANTA ANA
Escobedo 177
8:00, 11:00, 12:00, 19:00 y 20:00 hrs.
SANTA CLARA (SAGRADO CORAZÓN DE JESÚS)
Jardín Guerrero, Centro
8:00, 10:00, 12:00, 13:00, 14:00, 18:00, 19:00 y 20:00 hrs.
SANTIAGO
16 de Septiembre 56 Ote.
7:30, 9:00 y 12:00, 1:30, 18:00 y 19:30 hrs.
SANTUARIO DE NUESTRA SEÑORA DE EL PUEBLITO
Urtiaga s/n, El Pueblito, Corregidora
7:00, 8:00, 9:00, 11:00, 12:00,
13:00, 18:00, 19:00 y 20:00 hrs.
SANTUARIO DE SCHOENSTATT
Rancho Los Olvera, Corregidora 10:00 y 12:30 hrs.
Templos y capillas
CAPUCHINAS (SAN JOSÉ)
Hidalgo y Guerrero
12:30, 19:00, 20:00 y 21:00 hrs.
LA CONGREGACIÓN
Pasteur esq.
16 de Septiembre
10:00, 13:00, 14:00, 19:00 y 20:00 hrs.
LA DIVINA PROVIDENCIA
Zapata y Plan de Ayala
9:00, 13:00 y 18:30 hrs.
LA MERCED
Independencia 82
8:00, 10:30, 12:00, 13:00, 17:00, 18:00, 19:00 y 21:00 hrs.
LA SANTA CRUZ
Jardín de la Cruz
6:00, 7:00, 8:00, 9:00, 10:00, 12:00, 13:00, 14:00, 18:00, 19:00 y 20:00 hrs.
NUESTRA SEÑORA DE GUADALUPE
Paseo Jurica esq. Olivares 10:00, 12:00, 13:00 y 18:00 hrs.
NUESTRA SEÑORA DEL CARMEN
Juárez y Morelos
7:00, 8:00, 9:00, 11:00, 12:00, 13:00 y 20:00 hrs.
SAN AGUSTÍN
Pino Suárez 18
7:30, 8:30, 9:30, 10:30, 11:30, 12:30, 13:30, 14:15 y 20:00 hrs.
SAN ANTONIO
Ángela Peralta 16
8:30, 10:00, 12:30, 13:30, 17:30, 18:30, 19:30 y 20:30 hrs.
SAN FELIPE NERI (CATEDRAL)
Madero y Ocampo
11:00, 12:00, 13:00, 17:00, 18:00, 19:00 y 20:00 hrs.
SAN FRANCISCO
Corregidora esq. 5 de Mayo
7:00, 8:00, 9:00, 10:00, 11:00, 12:00, 13:00, 14:00, 18:00, 19:00, y 20:00 hrs.
SAN JOSÉ DE GRACIA
Madero 36
12:00, 13:00, 18:00 y 19:00 hrs.
SANTA ROSA DE VITERBO
Arteaga y Ezequiel Montes
7:00, 9:00, 11:00, 12:30, 18:00, 19:00 y 20:00 hrs.
SANTO DOMINGO
Pino Suárez y Guerrero
8:00, 12:00 y 19:00 hrs.
TERESITAS
Reforma 46
12:00, 19:00 y 20:00 hrs.
Prosiguiendo nuestro itinerario de la Catequesis con algunos modelos ejemplares de celo apostólico… recordemos que estamos hablando de evangelización, de celo apostólico, de llevar el nombre de Jesús, y hay muchas mujeres y hombres en la historia que lo han hecho de manera ejemplar. Hoy, por ejemplo, elegimos a san Francisco Javier, que es considerado, dicen algunos, como el más grande misionero de los tiempos modernos.

San Francisco Javier fue misionero durante once años más o menos. Los viajes en nave en aquella época eran durísimos y peligrosos. Muchos morían en el viaje por naufragios o enfermedades. Hoy, desgraciadamente mueren porque les dejamos morir en el Mediterráneo... Javier pasa en las naves más de tres años y medio, un tercio de la duración de su misión. En los barcos pasa más de tres años y medio, yendo a la India, y luego de la India a Japón.
Al llegar a Goa, en la India, la capital del Oriente portugués, la capital cultural y también comercial, Javier pone su base, pero no se detiene allí. Va a evangelizar a los pobres pescadores de la costa meridional de la India, enseñando catecismo y oraciones a los niños, bautizando y cuidando a los enfermos. Después, durante una oración nocturna ante la tumba del apóstol san Bartolomé, siente que debe ir más allá de la India. Deja en buenas manos el trabajo que ya había iniciado y zarpa con valentía hacia las Molucas, las islas más lejanas del archipiélago indonesio. Para esta gente, no había horizontes, iban más allá... ¡Qué valor tenían estos santos misioneros! También los de ahora, aunque no van en barco durante tres meses, van en avión durante 24 horas, pero, cuando llegan allí, es lo mismo. Hay que estar allí y recorrer tantos kilómetros, internarse en los bosques... Y Javier, en las Molucas, pone en verso y en el idioma local el catecismo y enseña a cantar el catecismo, que con el canto se aprende mejor. Por sus cartas, entendemos bien cuáles eran sus sentimientos. Escribe: “Los peligros y los sufrimientos, aceptados voluntariamente y únicamente por amor y servicio de Dios nuestro Señor, son
ricos tesoros de grandes consolaciones espirituales. ¡Aquí dentro de algunos años, uno podría perder los ojos por demasiadas lágrimas de alegría!” (20 de enero de 1548). Lloraba de alegría al ver la obra del Señor.
Un día, en India, se encuentra con un japonés que le habla de su lejano país, donde ningún misionero europeo había ido antes. Y Francisco Javier tenía la inquietud del apóstol, ir más lejos, más allá, y decide partir lo antes posible y llega después de un viaje lleno de aventuras en el junco de un chino. Los tres años en Japón son durísimos, por el clima, las oposiciones y el desconocimiento de la lengua, pero, también aquí, las semillas plantadas darán grandes frutos.
El gran soñador, Javier, en Japón, entiende que el país decisivo para la misión en Asia era otro: China, que, con su cultura, su historia, su grandeza, ejercía, de hecho, un predominio en toda esa parte del mundo. También hoy, China es un polo cultural con una gran historia, una hermosa historia... Por eso, vuelve a Goa y, poco después, se embarca de nuevo esperando poder entrar en China. Pero su plan fracasa: muere a las puertas de China en una isla, la pequeña isla de Sancián, frente a las costas de China esperando en vano poder desembarcar en tierra firme cerca de Cantón. El 3 de diciembre de 1522, muere en completo abandono, solo un chino junto a él a velarle. Así, termina el viaje terreno de Francisco Javier. Había envejecido, ¿cuántos años tenía? ¿Ochenta ya? No... Tenía solamente cuarenta y seis años, había pasado su vida en la misión, con celo. Dejó la culta España y llegó al país más culto del mundo en aquel momento, China, y murió ante la gran China, acompañado de un chino. ¡Todo un símbolo!
Su intensa actividad estuvo siempre unida a la oración, a la unión con Dios, mística y contemplativa.
La voz del vicario de Cristo
Foto: Armando Vázquez
El Polideportivo Arrasate de la Universidad Mondragón México, recibió la visita de autoridades estatales, municipales de El Marqués y educativas de la institución, que se congregaron para celebrar los 10 años de existencia de esta escuela.



Desde temprano, el deportivo registraba lleno total ante la develación de la placa conmemorativa, en la que cuerpo docente, alumnos y representantes de la Corporación Mondragón, rendían tributo a una escuela cuyos valores y misiones, se basarían en los preceptos de Don José María Arizmendiarrieta, figura determinante en el cause de la escuela.




La agenda cultural marcaría diversos eventos, como exposiciones culturales, food trucks, proyecciones en el auditorio con la historia y logros de la Universidad, entre otras actividades.
La velada cerraría con la participación de la Orquesta Sinfónica del Bajío, con un Concierto Sinfónico al aire libre, que cautivó a unos asistentes que nunca se despegaron de su asiento a pesar del frío y aire que corría por la noche.
Casi al finalizar el show, comenzaría el espectáculo de fuegos artificiales, que vivían en los cielos de la Universidad, creando una motivación apoteósica que contagiaba a los espectadores.


● Adriana Vega Vázquez Mellado - Secretaria de Turismo de Querétaro.
● Martha Elena Soto Obregón - Secretaria de Educación de Querétaro.
● Enrique Vega Carriles - Presidente Municipal de El Marqués
● Maria Guadalupe Murguía - Secretaria de Gobierno del estado.
● Iridia Salazar, Directora del INDEREQ.
● Virginia Hernández Vázquez - Secretaria de la Juventud en Qro.
● Zigor Ezpeleta Alberdi - Vicepresidente de la Corporación Mondragón.
● José María Cazalis - Delegado del gobierno vasco.
● María José Pagalday: Vicepresidente de la Corporación Mondragón.


● Josué Guerrero Tropola: Secretario Particular.
● Jon Altuna Vicerrector de Mondragon Unibertsitatea




● Bixente Atxa es Rector de Mondragon Unibertsitatea
● Íñigo Ucin Azcue - Presidente de la Corporación Mondragón.

● Arturo Alvarado Hierro - Rector de la Universidad Mondragón México


Con un programa de actividades, la Universidad Mondragón México festeja su décimo aniversario, en el que el invitado de lujo fue el gobernador de Querétaro, Mauricio Kuri.
